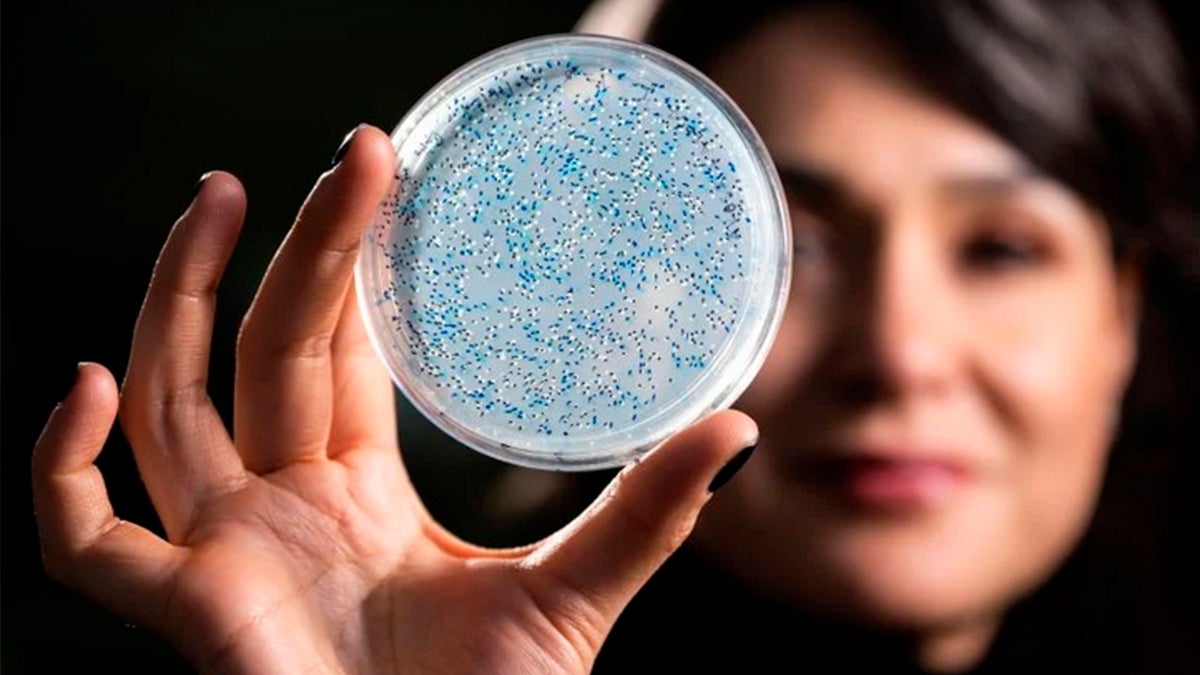

Tiene 3.200 millones de años y la clave para conocer el origen de la vida: ahora la han resucitado
Una enzima ancestral ha vuelto al laboratorio para ayudar a resolver una de las mayores preguntas de la ciencia...
Redirecting to full article...